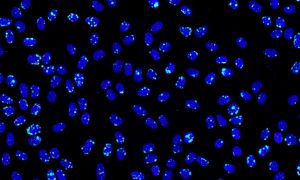
AI-generated microscopy image used to demonstrate how AI-generated image detection identifies synthetic cellular patterns.

AI-Generated Image Detection
Why AI-Generated Images Matter
AI-generated models have evolved significantly in the past few years and can now mimic scientific images with high fidelity – even microscopy textures and blot banding. Proofig AI detects AI-generated images early to help prevent desk rejections and retractions, and protect the credibility of your work. Like an immune system adapting to new pathogens, we continue to evolve as new threats emerge.
Data Misinterpretation
Synthetic images can alter how findings are perceived and evaluated.
Rejection or Retraction
May lead to editorial rejection before publication—or a formal retraction afterward.
Reputational Damage
Harms the credibility of authors, institutions, and journals alike.
Loss of Trust in Science
Erodes reader confidence and affects downstream research.
AI-Generated Image Categories We Detect
Proofig AI uses continuously updated multi-modal models to detect six key scientific image types, and works to increase coverage as new manipulation methods and threats emerge.
Microscopy

Histology

Cell Plates

Animal Imaging

Medical Scans

Western Blots & Gels
Think you can spot the AI fakes?
How It Works
Upload Your Manuscript Drag and drop your PDF or DOCX file—no formatting changes needed.
AI-Powered Analysis The system scans all images for potential issues—including AI-generated content.
Review and Validate Check flagged items, investigate further with forensic tools (e.g., color maps, Emboss, histogram equalization), and decide what to include.
Download a Final ReportGet a detailed PDF report you can use to uphold research integrity within your lab or team.
Industry-Leading AI Detection Accuracy
Microscopy
True Positives: 95.41%
False Positives: 0.0093%
Dataset: 200K real images
Western Blot
True Positives: 97.68%
False Positives: 0.0020%
Dataset: 250K real images
Trusted by Leading Institutions and Publishers












250K+ Manuscripts
Scanned using Proofig AI to uphold research integrity
Global
Trust
Adopted by top-tier publishers, journals, and research institutions
Seamless Integration
Integrated into pre-submission and editorial screening workflows
Integrity Support
Used by researchers, editors, and ethics officers worldwide
Proofig helped us catch issues we would’ve missed entirely.
High-Impact Journal
Further Resources
Proofig AI strengthens the submission and review process by automatically screening scientific images for suspected duplication, manipulation, AI-generated content, and plagiarism before peer review begins....
Image integrity issues are a documented trigger for desk rejection at major journals, and many of these issues are unintentional, arising during figure preparation or...
The world of scientific research is evolving at an unprecedented pace. Every day, new tools and technologies emerge to address challenges in research, publication, and...
In the realm of life science research, images play a pivotal role in communicating complex data. However, the integrity of these images can sometimes be...
Plagiarism is a critical ethical violation in academia and scientific research, threatening the foundation of knowledge and credibility. While it is often associated with students...
Scientific publishing is on the cusp of significant transformation, driven by historical trends and emerging technologies. By looking back at the evolution of scientific communication...






